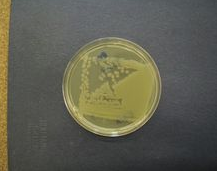

細菌培養細菌培養是一種用人工方法使細菌生長繁殖的技術。細菌在自然界中分布極廣,數量大,種類多,它可以造福人類,也可以成為致病的原因。大多數細菌可用人工方法培養,即將其接種于培養基上,使其生長繁殖。培養出來的細菌用于研究、鑒定和應用。細菌培養是一個復雜的技術。
中文名細菌培養培養條件37℃中放18~24小時生長實 質一個復雜的技術方 法人工方法目錄1培養條件
2注意點3具體培養步驟4日常管理和測試5培養成敗的標準6問題的分析和處理1培養條件培養時應根據細菌種類和目的等選擇培養方法、培養基,制定培養條件(溫度、pH值、時間,對氧的需求與否等)。一般操作步驟為先將標本接種于固體培養基上,做分離培養。再進一步對所得單個菌落進行形態、生化及血清學反應鑒定。培養基常用牛肉湯、蛋白胨、氯化鈉、葡萄糖、血液等和某些細菌所需的特殊物質配制成液體、半固體、固體等。一般細菌可在有氧條件下,37℃中放18~24小時生長。厭氧菌則需在無氧環境中放2~3天后生長。個別細菌如結核菌要培養1個月之久。
2注意點由于細菌無處不在,因此從制備培養基時開始,整個培養過程必須按無菌操作要求進行,否則外界細菌污染標本,會導致錯誤結果;而培養的致病菌一旦污染環境,就會引起交叉感染。
細菌培養以疾病診斷為目的進行的培養,要選擇合適的標本(血、尿、便、膿液、分泌物等),并應結合臨床情況解釋所得結果。
3具體培養步驟以光合細菌培養方法為例。光合細菌培養的方法,按次序分為容器、工具的消毒,培養基的制備,接種和培養管理四個步驟。
(一)容器、工具的消毒參考、此處從略。
(二)培養基的制備1.培養用水如果培養的光合細菌是淡水種,菌種培養可用蒸餾水,生產培養可用消毒的自來水(或井水)配制。如果培養的光合細菌是海水種,則用天然海水配制培養基,注意在海水中加入磷元素時,不能用磷酸氫二鉀,應用磷酸二氫鉀,不然會產生大量沉淀。
2.滅菌和消毒菌種培養用的培養基應連同培養容器用高壓蒸氣滅菌鍋滅菌。小型生產性培養可把配好的培養液用普通鋁鍋或大型三角燒瓶煮沸消毒。大型生產性培養則把經沉淀砂濾后的水用漂白粉(或漂白液)消毒后使用。
3.培養基配制根據所培養種類的營養需要選擇合適的培養基配方。按培養基配方把所需物質稱量,逐一溶解,混合,配成培養基。也可先配成母液,使用時按比例加入一定的量即可。
(三)接種培養基配好后,應立即進行接種。光合細菌生產性培養的按種量比較高,一般為20%~50%,即菌種母液量和新配培養液雖之比為1∶4~1∶1,不應低于20%,尤其是微氣培養,接種量更應高些,否則光合細菌在培養液中很難占絕對優勢,影響培養的最終產量和質量。
(四)培養管理光合細菌的培養過程中,管理工作包括日常管理操作和測試,生長情況的觀察、檢查以及出現問題的分析處理等三個方面。
4日常管理和測試(1)攪拌和充氣:光合細菌培養過程中必須充氣或攪拌,作用是幫助沉淀的光合細菌上浮獲得光照,保持菌細胞的良好生長。小型厭氣培養常用人工搖動培養容器的方法使菌細胞上浮,每天至少搖動三次,定時進行。大型厭氣培養則用機械攪拌器或使用小水泵使水緩慢循環運轉,保持菌體懸浮。微氣培養是通過充氣幫助菌體上浮,因為培養液中溶解氧含量增加,光合細菌繁殖受到抑制,產量下降,所以必須嚴格控制充氣量。一般采用定時斷續充氣,充氣量控制在1~1.5升/(升·h)之間,溶解氧量保持在1×10-6以下。
(2)調節光照度:培養光合細菌需要連續進行照明。在日常管理工作中,應根據需要經常調整光照度。白天可利用太陽光培養,晚上則需要人工光源照明,或完全利用人工光源培養。人工光源一般使用碘鎢燈或白熾燈泡。不同的培養方式所要求的光照強度有所不同。一般培養光照強度應控制在2000~5000lx之間。如果光合細菌生長繁殖快,細胞密度高,則光照強度應提高到5000~10000lx。光照強度可通過調整培養容器與光源的距離或使用可控電源箱調節。
(3)調節溫度:光合細菌對溫度的適應范圍很廣,一船在23~39℃的范圍內均能正常生長繁殖,可不必調整溫度。在常溫下培養也可通過調整,將溫度控制在光合細菌生長繁殖最適宜的范圍內,使光合細菌更好地生長。
(4)酸堿度的測定和調整:在培養光合細菌的過程中,必須注意酸堿度的變化。由于光合細菌的大量繁殖,菌液的pH值上升,這意味著光合細菌正處于指數生長期。但當pH值超過最適范圍甚至生長的適應范圍時,光合細菌的生長達到頂點,隨后生長下降。如果能及時調整菌液的酸堿度,使pH值保持在最適范圍,則光合細菌能繼續生長繁殖。為了延長光合細菌的指數生長期,提高培養基的利用率和單位水體的產量,測定和調整PH值是非常重要的。一船采用加酸的辦法來降低菌液的酸堿度,醋酸、乳酸和鹽酸部可使用,最常用的是醋酸。在日常的管理工作中,必須每天或隔天測定菌液的pH值,當pH值上升超出最適范圍,即加酸調整。如果在培養過程中不測定、調整酸堿度,當光合細菌的生長達到一定密度后pH值也上升到9以上,細菌生長受阻,此時應采收或再擴大培養。在培養過程中不調整PH值,獲得的最終產量低。
5培養成敗的標準生長情況的觀察和檢查光合細菌生長情況的好壞是培養成敗的標準。在培養過程中,可以通過觀察菌液的顏色及其變化來了解光合細菌生長繁殖的大體情況,菌液的顏色是否正常,接種后顏色是否由淺變深,均反映光合細菌是否正常生長繁殖以及繁殖速度的快慢。必要時可通過顯微鏡檢查,了解情況。
6問題的分析和處理通過日常管理、檢測、檢查,了解光合細菌的生長情況,就可以結合當時環境條件的變化進行分析,找出影響光合細菌生長繁殖的原因,采取相應的措施。影響光合細菌生長的原因很多,內因是菌種是否優良,外因是光照、溫度、營養、敵害和厭氣程度等。溫度、光照和pH值都能影響著光合細菌的生長,而且溫度、光照和pH值之間是互相制約的,溫度與光照的強弱是對立統一的,所以光合細菌生長的最適條件應是互應的,即溫度高,光照應弱;溫度低,光照應強。如果是溫度高,光照強,pH值就會迅速升高,培養基產生沉淀,抑制光臺細菌的生長;如果溫度低,光照弱,光合細菌得不到最佳能源,生長速度也慢。經試驗得出光合細菌生長的最適條件是:①溫度15~20℃時,光照30000~50000lx,培養基pH值為7.0;②溫度25~30℃時,光照為3000~5000lx,培養基的pH值為7.0。